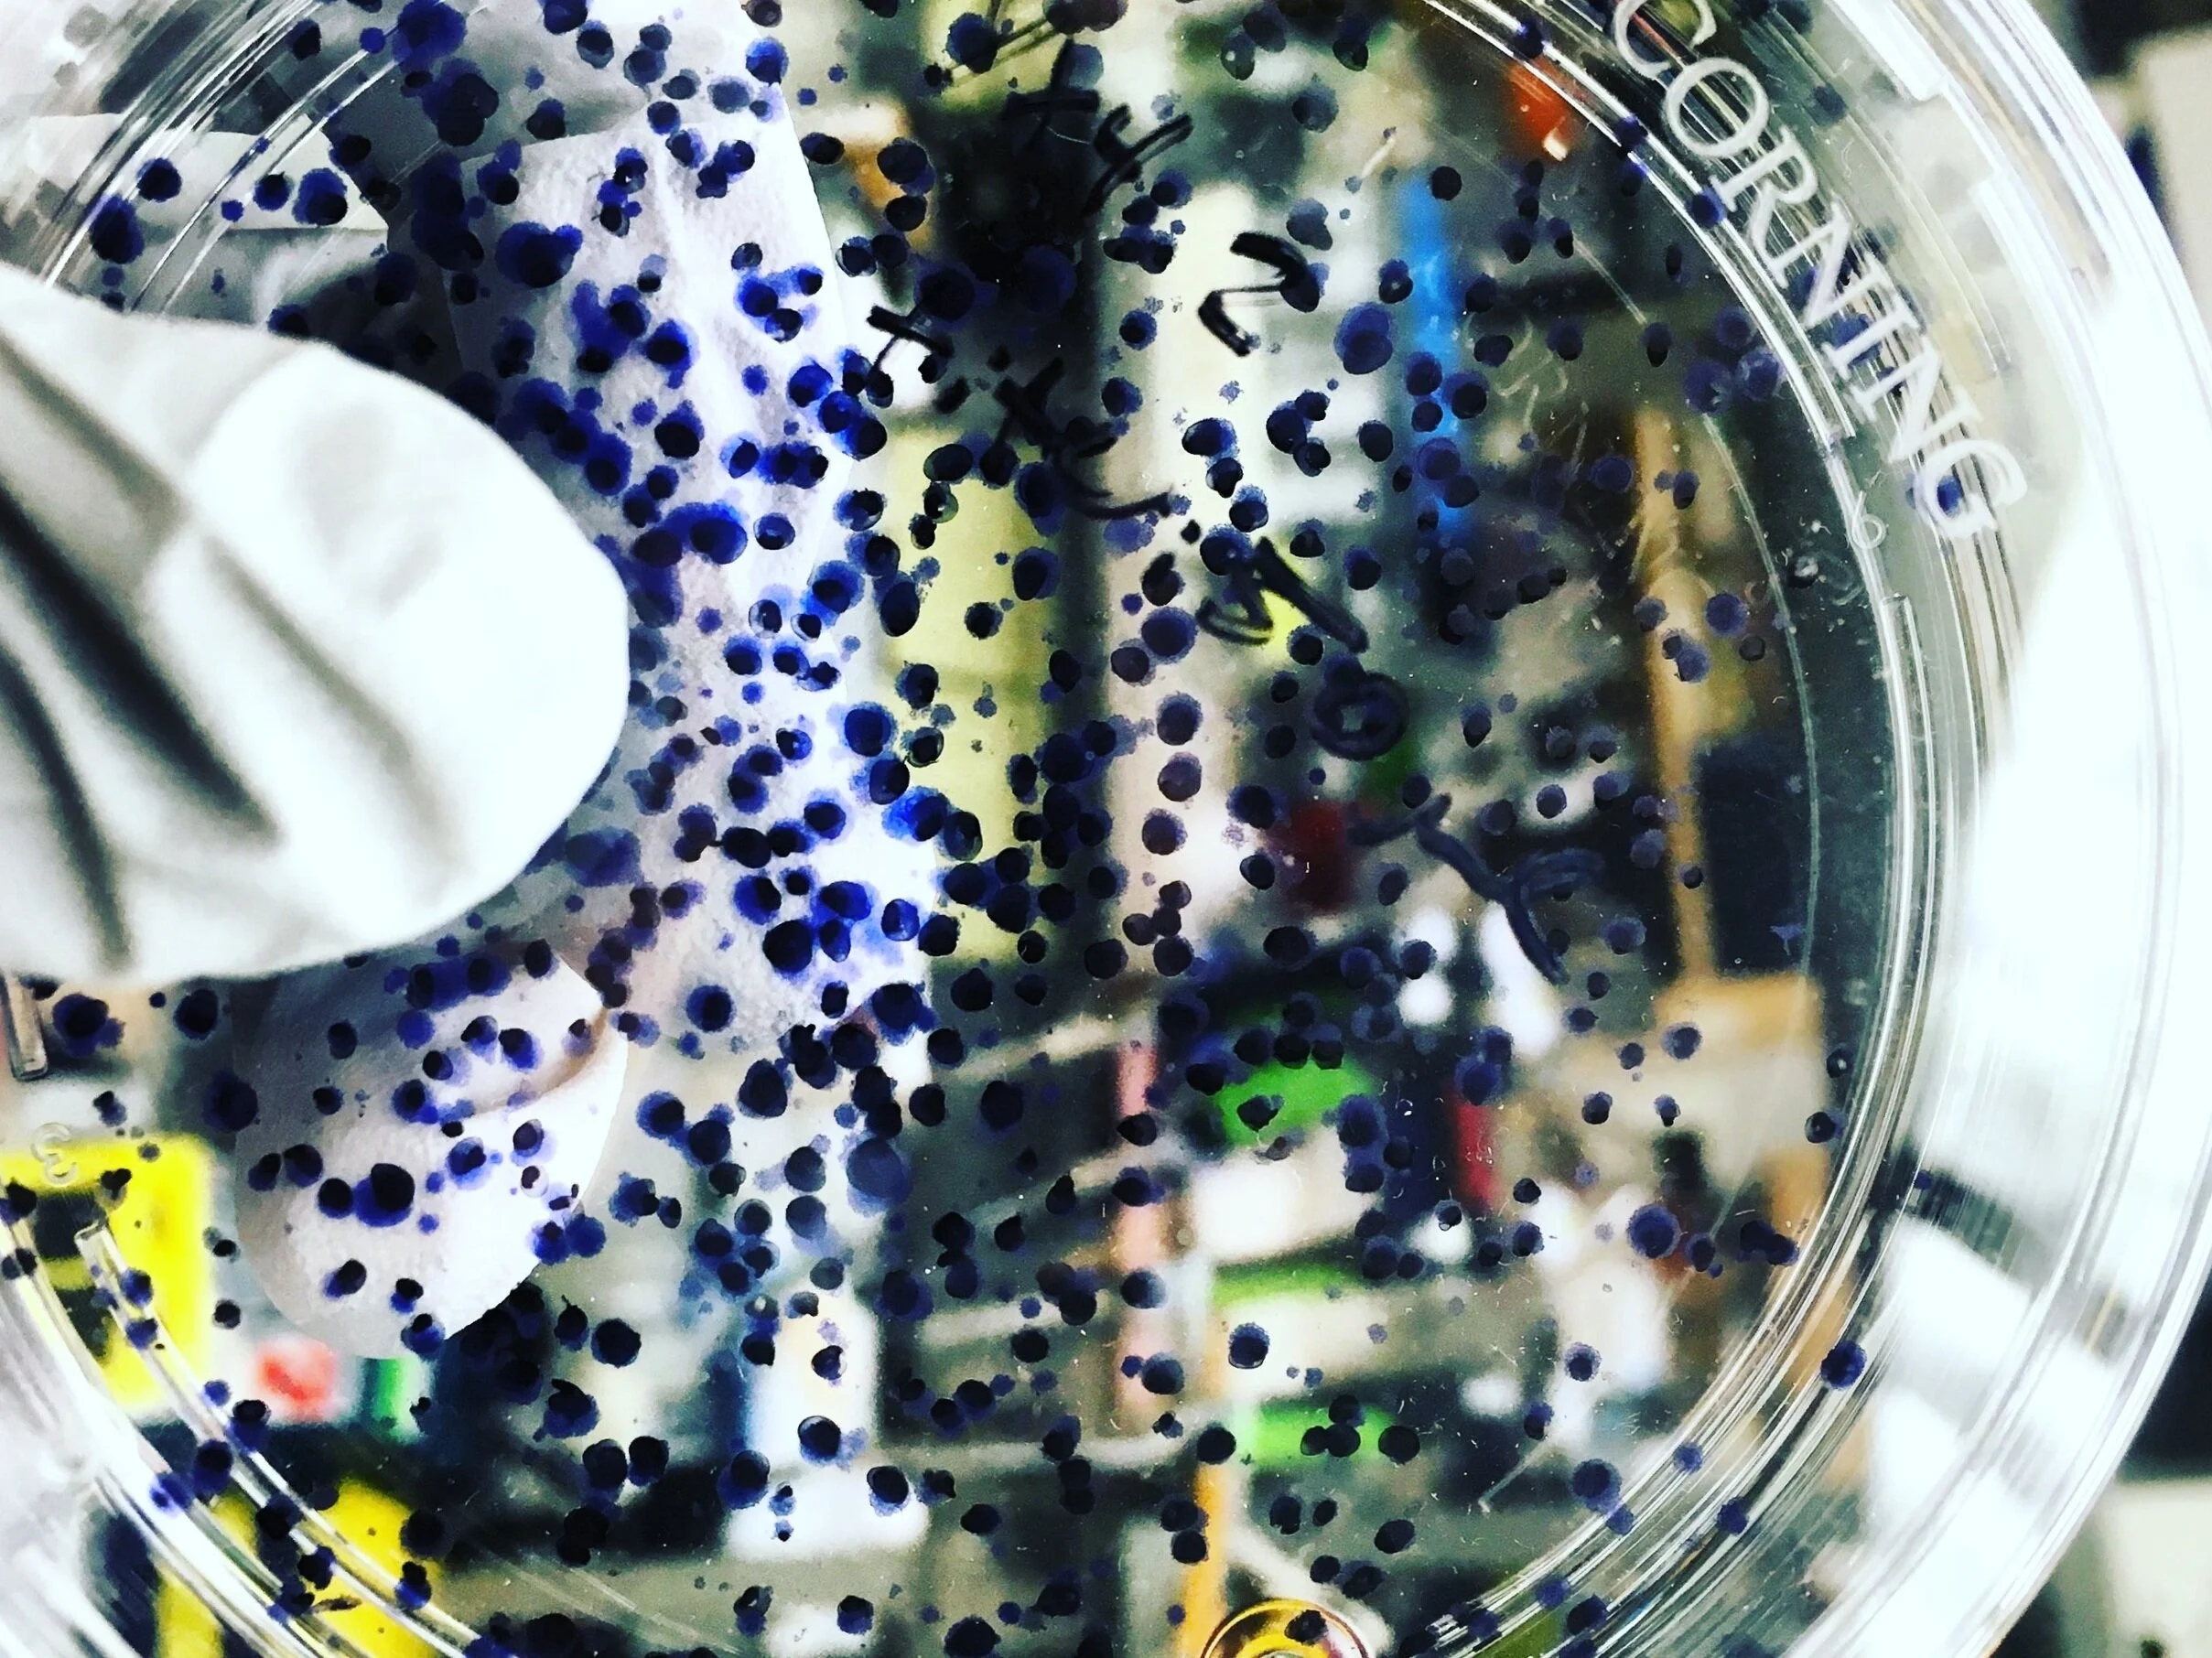
IMG_4541.jpeg

I am currently an NIH-funded MD-PhD student in the Harvard-MIT Health Sciences and Technology MD program. I work in the Schmidt Lab for my PhD as a student in the Harvard Chemical Biology program, where I study all sorts of RNA viruses like dengue and influenza.
In my copious free time, I am a resident tutor at Lowell House, a Harvard College residential living community where I work closely with premedical and queer students. I find joy singing with various groups around Boston and working with HST to implement more focused and inclusive teaching about the medical needs of queer and gender-diverse communities. I am also a tutor at Cambridge Coaching, a photographer, and an avid compiler of incredibly detailed note-sheets that I probably should’ve spent more time studying.

As an undergraduate, I earned a B.S. and M.S. in Molecular Biophysics and Biochemistry.
I graduated
Cum Laude, with Distinction in the Major, and was the 2020
Paul Sigler Prize Awardee; a selected departmental peer mentor; and a 2019 Grace Hopper College Richter Fellowship Awardee.
I did my research under Dr. DiMaio in the DiMaio Lab, and my thesis was “Transmembrane Protein Terms and Conditions: Genetically and Linguistically Screening Simple Transmembrane Proteins to Reveal Principles of Protein Interactions.”
I also earned a B.A. in English Language and Literature, where I focused on world literature and postcolonial theory. I also graduated with Distinction in the English Major.
My thesis advisor was Dr. Jill Richards, and my thesis was a case-study of the relationship between fictional narrative and historical memory in anglophone world literature, called “How to Swallow the World: Magical Realism and Postcolonial Narratives in Salman Rushdie’s ‘Midnight’s Children’.”
President, Yale Undergraduate Research Association (2018-20)
Musical Director, New Blue of Yale A Cappella (2016-19) [spotify] [youtube]
Assistant Musical Director, Whim N’ Rhythm A Cappella (2019-20) [spotify] [youtube]
Volunteer, Planned Parenthood, Yale-New Haven
Hospital, HAVEN Free Clinic (2019 - 20)

Space Life Sciences Training Program
I worked under Dr. John Hogan on research related to Life Support and Habitation. Over the course of the summer, I designed the fundamentals of a protein
purification system to enable in-space bio-manufacturing
SLSTP Group Project
Astrobiology: Coordinated biological sampling, grant-writing, photography, videography and outreach for high-altitude balloon investigation of associations between black carbon and
microbial life in the upper stratosphere. [video]

Lead Investigator: GENES IN SPACE - 1, A NASA/CASIS Payload
"Dawn of the Molecular Space Age” - Dr. Wallace, NASA JSC
Validated PCR on ISS: Established functional basis for a PCR-based assay to
evaluate epigenetic changes in the human immune system in space.
Genes in Space Program Ambassador
I’ve spoken in classrooms, at conferences, helped MiniPCR staff their Genes in Space booth and NASA with their CASIS booth (incl. SXSW Edu. 2018, Nat’l Science and Engineering Festival, ISSRDC, and other educational conferences) and otherwise contributed to program outreach.
Genes in Space 2021 Judge
I served as a judge for the 2021 iteration of the Genes in Space contest

Advisor: Dr. Kiran Nistala
Conducted research into the molecular basis of rare genetic diseases and disorders
Summer 2017: Supervised High School Mentorship student.

Advisor: Dr. Lori Sussel
Investigated the role of CHD4 in islet beta cell differentiation.
- 2016 Intel Science Talent Search Semifinalist
- 2016 Junior Science and Humanities Symposium State Winner, Molecular Biology
- 2016 Junior Science and Humanities Symposium National Qualifier